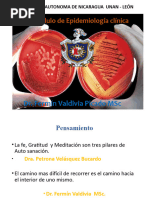

Catedra: APS II
ATENCIÓN PRIMARIA DE LA SALUD II
DOCENTE: Prof. Mg. Monteverde M. Gabriela
ACTIVIDAD OBLIGATORIA – AREA TEORICA
CONSIGNA: EL ALUMNO DEBERA REALIZAR UN ANALISIS DE SITUACION (ASIS) SOBRE UN TEMA
DE SALUD. DICHO EVENTO DE SALUD SERA DE ELECCION DEL ALUMNO, BAJO LOS CRITERIOS
DESCRIPTOS EN EL CIE 10, CAPITULO 1 (ver Anexo).
DEBERA SEGUIR LOS PASOS DE LA GUIA PARA ELABORACION DEL ANALISIS DE SITUACION DE
LA SALUD EN ATENCION PRIMARIA, DETALLADOS EN EL PUNTO 2 (dos), SOBRE SU TEMA DE
ELECCION. DEBERA ESPECIFICAR EVENTO/ENFERMEDAD Y REGION (BARRIO, CIUDAD, ESTADO,
PROVINCIA Y PAIS), PARA LA REALIZACION DEL “ASIS”. POR EJEMPLO: CHAGAS EN LA
PROVINCIA DE SANTIAGO DEL ESTERO, ARGENTINA.
ENCONTRARA LOS LINEAMIENTOS DE CONTROL Y PREVENCION DE ENFERMEDADES (CDC),
ACCEDIENDO A [Link]
DICHO TRABAJO PODRA REALIZARSE DE FORMA INDIVIDUAL O GRUPAL, INTEGRADO POR NO
MAS DE 3 ALUMNOS.
DEBERA CONTENER CARATULA, APELLIDOS Y NOMBRES DE LOS ALUMNOS PARTICIPANTES,
COMISION Y FECHA DE ENTREGA. FORMATO PAPEL A 4, TEXTO ARIAL 11. EL TRABAJO NO
DEBERA SUPERAR UN MAXIMO 5 (CINCO) CARILLAS.
FECHA DE ENTREGA: 11/05/2019. ENVIAR POR MAIL A [Link]@[Link]
1) Introducción
Lograr hacer un diagnóstico situación en medicina significa averiguar el estado de salud de una
persona y en el caso de padecer una dolencia o enfermedad (evento de salud), determinar las
causas y las necesidades más urgentes para su restablecimiento. Si esto se traslada a la realidad
de una comunidad, hacer un diagnóstico será averiguar el estado de dicha comunidad, detectar
los problemas que padece y buscar una solución y/o mejora a los problemas de mayor
relevancia. El diagnóstico de situación es un método eficaz a aplicar para terminar con la falta
de comunicación, de experiencias y conocimientos entre los miembros de una comunidad.
Entonces se define al diagnóstico como el procedimiento por el cual se establece la naturaleza
y la magnitud de las necesidades o problemas que afectan a una comunidad.
¿Qué utilidades tiene el hacer un diagnóstico?
-Permite identificar el desarrollo histórico de la comunidad.
-Posibilita identificar los problemas y necesidades más relevantes y actuar con conocimiento
pleno sobre esa realidad.
1
�-Contribuye a motivar a la comunidad a identificar su realidad y a ganar niveles de conciencia
sobre su papel transformador.
-Se constituye en un proceso de aprendizaje colectivo a partir del dialogo de saberes.
-Promueve los niveles de comunicación y participación de la comunidad.
-Permite desconcentrar poder y empoderar a la comunidad.
-Genera autonomía para mejorar condiciones sociales.
-Ayuda a cohesionar a la comunidad para actuar colectivamente.
2) Lea atentamente cada punto para realizar el ANALISIS DE SITUACION.
Guía para la elaboración del análisis de la situación de salud en la atención primaria
El análisis de la situación de salud es una práctica necesaria en la Atención Primaria de Salud,
cuyo propósito es la identificación y el grado de prioridad de los problemas de salud de la
comunidad para desarrollar acciones que contribuyan a su solución. El objetivo de este trabajo
es presentar una guía para realizar ese análisis en la comunidad.
El análisis de la situación de salud (ASIS) es una actividad necesaria en la APS, que tiene como
propósito identificar las características socio psicológicas, económicas, históricas, geográficas,
culturales y ambientales que inciden en la salud de la población, así como los problemas de salud
que presentan los individuos, las familias, los grupos y la comunidad en su conjunto, para
desarrollar acciones que contribuyan a su solución.
La importancia de la elaboración del ASIS en cada uno de los Centros de salud, Instituciones
educativas, con la colaboración de sus representantes de la población, constituye el elemento
base para la planificación estratégica a ese nivel, y establece las prioridades, pues dispone de los
recursos locales en función de ellos. El ASIS es una práctica habitual en la APS, que tiene como
propósito básico entender las causas y consecuencias de los diferentes problemas de salud en
la comunidad, y se concibe como un tratamiento interdisciplinario y flexible en su aplicación.
FORMATO DE PRESENTACION DE LA ACTIVIDAD:
La guía para la confección del ASIS consta de los componentes siguientes:
1. Descripción de la situación socio histórica y cultural del territorio.
2. Caracterización sociodemográfica de la población.
3. Identificación de los riesgos a nivel comunitario, familiar e individual.
4. Descripción de los servicios de salud existentes y análisis de las acciones de salud
realizadas.
5. Descripción y análisis de los daños y problemas de salud de la población.
6. Análisis de la participación de la población en la identificación y solución de los
problemas de salud.
7. Análisis de la intersectorialidad en la gestión de salud en la comunidad.
8. Tratamiento metodológico de la información.
9. Situación de salud de la comunidad.
10. Elaboración del plan de acción.
[Link] (ver punto 3, abajo detallado)
2
� El fundamento teórico de la guía lo constituye la concepción holística y social de la salud, en la
cual se considera la salud como una totalidad de componentes de orden biológico, psicológico,
ambiental, cultural y socioeconómico que interactúan entre sí como una red de múltiples
influencias internas y externas, y no como compartimentos que influyen en forma lineal en la
totalidad, ni como la sumatoria de factores.
Cada componente puede ser desarrollado de forma cuantitativa y cualitativa, según su
contenido lo requiera y de acuerdo con el modo en que se exprese en la población y en el
territorio. Es válido destacar que si se realiza el ASIS por primera vez en una comunidad, requiere
de una indagación profunda de los aspectos geográficos, históricos y culturales que la
caracterizan, no así cuando el equipo de salud ha realizado varios ASIS en la comunidad.
3) Finalmente deberá realizar una conclusión, con la información recolectada, justificándola
con sus conocimientos de Atención Primaria de la Salud.
Se le sugiere para finalizar su conclusión, el planteo objeto, aportes de sus propias
percepciones y sugerencias en post de la mejora, sobre el tema “evento de salud”
elegido.
3
�ANEXO CIE 10.
Clasificación Internacional de Enfermedades 10° CIE 10° REVISION
Definición: Una clasificación de enfermedades puede definirse como “Sistema de categorías a las cuales
se les asignan entidades morbosas de acuerdo con criterios establecidos “. Propósito: Permitir el registro
sistemático, el análisis, la interpretación y la comparación de los datos de mortalidad y morbilidad
recolectados en diferentes países o áreas y en diferentes épocas.
Utilidad: Convertir los términos diagnósticos y de otros problemas de salud, de palabras a códigos
alfanuméricos que permiten su fácil almacenamiento y posterior recuperación para el análisis de la
información.
En la práctica se ha convertido en una clasificación diagnóstica estándar internacional para todos los
propósitos epidemiológicos generales y muchos otros de administración de salud. La C.I.E., no es
adecuada para indagar entidades clínicas individuales y es adecuada para clasificar enfermedades y otros
tipos de problemas de salud, consignados en distintos tipos de registros vitales y de salud. Estructura
básica de la C.I.E. 10ª Revisión La C.I.E. es un sistema de clasificación de ejes variables cuyo esquema debe
servir a todos los propósitos prácticos y epidemiológicos. Este patrón puede ser identificado en los
capítulos de la C.I.E. y hasta el momento es considerado como la estructura más útil que cualquiera de las
alternativas que se han probado.
La C.I.E. utiliza un código alfanumérico, con una letra en la 1° posición y números en la 2°,3°, y 4° posición;
el cuarto carácter sigue a un punto decimal, los códigos posibles van por lo tanto de A00.0 a Z99.9.
Se usaran para la clasificación los egresos en el ANEXO II de la Resolución Ministerial 487/02 las tres
primeras posiciones (ejemplo de A00 a Z99) 2
Afección o códigos principales: Se define como la afección diagnóstica al final del proceso de atención de
la salud cómo la causante primaria de la necesidad de tratamiento o investigación que tuvo el paciente.
Si hay más de una afección así caracterizada, debe seleccionarse la que se considera causante del mayor
uso de recursos.
Otras afecciones u otros códigos Se definen como aquellas que coexistieron o se desarrollaron durante el
episodio de atención y afectaron el tratamiento del paciente. Las afecciones que hayan afectado
anteriormente al paciente pero que no inciden en el episodio actual no se deben registrar.
CAPITULO I
CIERTAS ENFERMEDADES INFECCIOSAS Y PARASITARIAS
Enfermedades infecciosas intestinales
A00 Cólera
A01 Fiebres tifoidea y paratifoidea
A02 Otras infecciones debidas a Salmonella
A03 Shigelosis
A04 Otras infecciones intestinales bacterianas
A05 Otras intoxicaciones alimentarias bacterianas
A06 Amebiasis
A07 Otras enfermedades intestinales debidas a protozoarios
A08 Infecciones intestinales debidas a virus y otros organismos especificados
A09 Diarrea y gastroenteritis de presunto origen infeccioso
Tuberculosis
A15 Tuberculosis respiratoria, confirmada bacteriológica e histológicamente
A16 Tuberculosis respiratoria, no confirmada bacteriológica o histológicamente
A17 Tuberculosis del sistema nervioso
A18 Tuberculosis de otros órganos
A19 Tuberculosis miliar
Ciertas zoonosis bacterianas
A20 Peste
4
�A21 Tularemia
A22 Carbunco [ántrax]
A23 Brucelosis
A24 Muermo y melioidosis
A25 Fiebres por mordedura de rata
A26 Erisipeloide
A27 Leptospirosis
A28 Otras enfermedades zoonoticas bacterianas, no clasificadas en otra parte
Otras enfermedades bacterianas
A30 Lepra [enfermedad de Hansen]
A31 Infecciones debidas a otras micobacterias
A32 Listeriosis
A33 Tétanos neonatal
A34 Tétanos obstétrico
A35 Otros tétanos
A36 Difteria
A37 Tos ferina [tos convulsiva]
A38 Escarlatina
A39 Infección meningococica
A40 Septicemia estreptococica
A41 Otras septicemias
A42 Actinomicosis
A43 Nocardiosis
A44 Bartonelosis
A46 Erisipela
A48 Otras enfermedades bacterianas, no clasificadas en otra parte
A49 Infección bacteriana de sitio no especificado
Infecciones con modo de transmisión predominantemente sexual
A50 Sífilis congénita
A51 Sífilis precoz
A52 Sífilis tardía
A53 Otras sífilis y las no especificadas
A54 Infección gonococica
A55 Linfogranuloma (venéreo) por clamidias
A56 Otras enfermedades de transmisión sexual debidas a clamidias
A57 Chancro blando
A58 Granuloma inguinal
A59 Tricomoniasis
A60 Infección anogenital debida a virus del herpes (herpes simple)
A63 Otras enfermedades de transmisión predominantemente sexual, no clasificadas en otra parte
A64 Enfermedad de transmisión sexual no especificada
Otras enfermedades debidas a espiroquetas
A65 Sífilis no venérea
A66 Frambesia
A67 Pinta [carate]
A68 Fiebres recurrentes
A69 Otras infecciones causadas por espiroquetas
Otras enfermedades causadas por clamidias
A70 Infección debida a Chlamydia psittaci
A71 Tracoma
A74 Otras enfermedades causadas por clamidias
Rickettsiosis
A75 Tifus
A77 Fiebre maculosa (rickettsiosis transmitida por garrapatas)
5
�A78 Fiebre Q
A79 Otras rickettsiosis
Infecciones virales del sistema nervioso central
A80 Poliomielitis aguda
A81 Infecciones del sistema nervioso central por virus lento
A82 Rabia
A83 Encefalitis viral transmitida por mosquitos
A84 Encefalitis viral transmitida por garrapatas
A85 Otras encefalitis virales, no clasificadas en otra parte
A86 Encefalitis viral, no especificada
A87 Meningitis viral
A88 Otras infecciones virales del sistema nervioso central, no clasificadas en otra parte
A89 Infección viral del sistema nervioso central, no especificada
Fiebres virales trasmitidas por artrópodos y fiebres virales hemorrágicas
A90 Fiebre del dengue [dengue clásico]
A91 Fiebre del dengue hemorrágico
A92 Otras fiebres virales transmitidas por mosquitos
A93 Otras fiebres virales transmitidas por artrópodos, no clasificadas en otra parte
A94 Fiebre viral transmitida por artrópodos, no especificada
A95 Fiebre amarilla
A96 Fiebre hemorrágica por arenavirus
A98 Otras fiebres virales hemorrágicas, no clasificadas en otra parte
A99 Fiebre viral hemorrágica, no especificada
Infecciones virales caracterizadas por lesiones de la piel y de las membranas mucosas
B00 Infecciones herpéticas [herpes simple]
B01 Varicela
B02 Herpes zoster
B03 Viruela
B04 Viruela de los monos
B05 Sarampión
B06 Rubeola [sarampión alemán]
B07 Verrugas víricas
B08 Otras infecciones víricas caracterizadas por lesiones de la piel y de las membranas mucosas, no
clasificadas en otra parte
B09 Infección viral no especificada, caracterizada por lesiones de la piel y de las membranas mucosas
Hepatitis viral
B15 Hepatitis aguda tipo A
B16 Hepatitis aguda tipo B
B17 Otras hepatitis virales agudas
B18 Hepatitis viral crónica
B19 Hepatitis viral, sin otra especificación
Enfermedad por virus de la inmunodeficiencia humana (HIV)
B20 Enfermedad por virus de la inmunodeficiencia humana [VIH], resultante en enfermedades
infecciosas y parasitarias
B21 Enfermedad por virus de la inmunodeficiencia humana [VIH], resultante en tumores malignos
B22 Enfermedad por virus de la inmunodeficiencia humana [VIH], resultante en otras enfermedades
especificadas
B23 Enfermedad por virus de la inmunodeficiencia humana [VIH], resultante en otras afecciones
B24 Enfermedad por virus de la inmunodeficiencia humana [VIH], sin otra especificación
Otras enfermedades virales
B25 Enfermedad debida a virus citomegalico
B26 Parotiditis infecciosa
B27 Mononucleosis infecciosa
B30 Conjuntivitis viral
B33 Otras enfermedades virales, no clasificadas en otra parte
6
�B34 Infección viral de sitio no especificadotr
Micosis
B35 Dermatofitosis
B36 Otras micosis superficiales
B37 Candidiasis
B38 Coccidioidomicosis
B39 Histoplasmosis
B40 Blastomicosis
B41 Paracoccidioidomicosis
B42 Esporotricosis
B43 Cromomicosis y absceso feomicotico
B44 Aspergilosis
B45 Criptococosis
B46 Cigomicosis
B47 Micetoma
B48 Otras micosis, no clasificadas en otra parte
B49 Micosis, no especificada
Enfermedades debidas a protozoarios
B50 Paludismo [malaria] debido a Plasmodium falciparum
B51 Paludismo [malaria] debido a Plasmodium vivax
B52 Paludismo [malaria] debido a Plasmodium malaria
B53 Otro paludismo [malaria] confirmado parasitológicamente
B54 Paludismo [malaria] no especificado
B55 Leishmaniasis
B56 Tripanosomiasis africana
B57 Enfermedad de Chagas
B58 Toxoplasmosis
B59 Neumocistosis
B60 Otras enfermedades debidas a protozoarios, no clasificadas en otra parte
B64 Enfermedad debida a protozoarios, no especificada
Helmintiasis
B65 Esquistosomiasis [bilharziasis]
B66 Otras infecciones debidas a tremátodos
B67 Equinococosis
B68 Teniasis
B69 Cisticercosis
B70 Difilobotriasis y esparganosis
B71 Otras infecciones debidas a cestodos
B72 Dracontiasis
B73 Oncocercosis
B74 Filariasis
B75 Triquinosis
B76 Anquilostomiasis y necatoriasis
B77 Ascariasis
B78 Estrongiloidiasis
B79 Tricuriasis
B80 Enterobiasis
B81 Otras helmintiasis intestinales, no clasificadas en otra parte
B82 Parasitosis intestinales, sin otra especificación
B83 Otras helmintiasis
Pediculosis. Acariasis y otras manifestaciones
B85 Pediculosis y pithiriasis
B86 Escabiosis
B87 Miasis
B88 Otras infestaciones
7
�B89 Enfermedad parasitaria, no especificada
Secuelas de enfermedades infecciosas y parasitarias
B90 Secuelas de tuberculosis
B91 Secuelas de poliomielitis
B92 Secuelas de lepra
B94 Secuelas de otras enfermedades infecciosas y parasitarias y de las no especificadas
Bacterias, virus y otros agentes infecciosos
B95 Estreptococos y estafilococos como causa de enfermedades clasificadas en otros capítulos
B96 Otros agentes bacterianos como causa de enfermedades clasificadas en otros capítulos
B97 Agentes virales como causa de enfermedades clasificadas en otros capítulos
Otras enfermedades infecciosas
B99 Otras enfermedades infecciosas y las no especificadas




![5
A21 Tularemia
A22 Carbunco [ántrax]
A23 Brucelosis
A24 Muermo y melioidosis
A25 Fiebres por mordedura de rata
A26 E](https://screenshots.scribd.com/Scribd/252_100_85/356/422038606/5.jpeg)